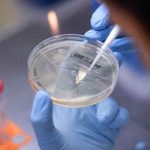
Detectan en Brasil una nueva variante del coronavirus brasil, coronavirus, deteccion, variante, cientificos,

Etiqueta: deteccion
Detectan en Brasil una nueva variante del coronavirus
Científicos brasileños han identificado una nueva cepa de coronavirus SARS-Cov-2 que de momento está circulando por el interior del estado de São Paulo.
Según el...
La sonda Voyager 1 transmite a la Tierra el zumbido del gas interestelar
Instrumentos aún en funcionamiento a bordo de la sonda interestelar Voyager 1 de la NASA, lanzada hace 44 años, han detectado el zumbido constante...
Estos son los síntomas que ocultan enfermedades cardiovasculares
Las enfermedades cardíacas son la principal causa de muertes en el mundo, pero existen algunos síntomas que podrían ayudar a detectarlas a tiempo.
Un médico...
El telescopio TBT2 detectará asteroides peligrosos para la Tierra
Emplazado en el Observatorio de La Silla, en el desierto de Atacama, en el norte de Chile, el innovador telescopio TBT2 tendrá la misión...
Detectan una rareza cósmica: dos cuásares dobles en galaxias en fusión
Es como encontrar una aguja en un pajar. Un grupo de astrónomos ha detectado dos cuásares dobles, que están más cerca entre sí que...
Pruebas genéticas de VPH son claves para detectar el cáncer cervicouterino
La aplicación de pruebas genéticas del Virus del Papiloma Humano (VPH) como complemento al papanicolaou ayudaría a detectar hasta un 24 % más el...
Hospital San Juan de Dios de Estelí realizó jornada de endoscopía
En horas de la mañana del martes 9 de marzo, en el Hospital Escuela San Juan de Dios de Estelí, se realizó una jornada...
Indonesia usa «narices electrónicas» para detectar la covid-19
Las autoridades de Indonesia han comenzado a usar unos aparatos especiales que funcionan como narices electrónicas para detectar la covid-19 a través del aliento,...
Virufy: La app para detectar COVID-19 desde el celular con solo toser
Jóvenes profesionales de 20 países y representantes de prestigiosas universidades del mundo desarrollaron Virufy, una aplicación que permite diagnosticar COVID-19 mediante el análisis de...
Nicaragua fortalece trabajo sobre el cuido a la niñez con discapacidad
El Ministerio de Salud este miércoles desarrolló un taller sobre la intervención temprana en niños y niñas con discapacidad en el Instituto Tecnológico de la Salud.
Dicho...